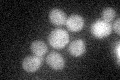
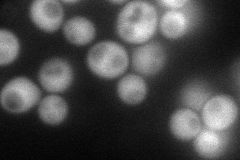
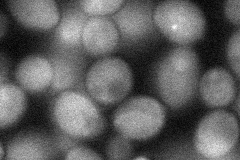
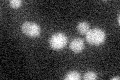

View description
Protein that interacts with CCT (chaperonin containing TCP-1) complex and has a role in actin and tubulin folding; has weak similarity to phosducins, which are G-protein regulators
Localization:
Intensity:
Fold change:
Significance:
-
C’ GFP library in SD
cytosol22.73 -
N' NOP1pr-GFP in SD
cytosol104.28 -
N' TEF2pr-mCherry in SD

cytosol173.484 -
N' NATIVEpr-GFP in SD

below threshold16.7626 -
N' TEF2pr-VC and Cyto-VN in SD
cytosol50.3727 -
C’ GFP library in SD+DTT

cytosol23.421.03No -
C’ GFP library in SD+H2O2

cytosol18.070.79No -
C’ GFP library in Starvation Media
cytosol21.830.96No -
C’ GFP library on the background of Pup2-DaMP

cytosol -
C’ GFP library on the background of CCT mutant

cytosol21.01750.924286No
